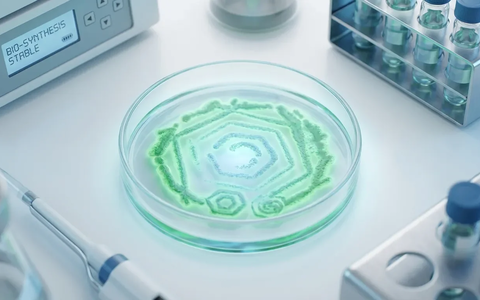
Postbiotika erobern den Gesundheitsmarkt - Foto: über boerse-global.de

Thema: Postbiotika
Darmgesundheit, Personalisierte

Darmgesundheit 2026: Personalisierte Mikrobiom-Analysen lösen Standard-Probiotika ab - Foto: über boerse-global.de

Darmgesundheit 2026: Personalisierte Mikrobiom-Analysen lösen Standard-Probiotika ab
boerse-global.de, 30.01.26 19:14 Uhr
Hautpflege, Mikrobiom
Die Kosmetikindustrie setzt auf Postbiotika und Präbiotika ...
Hautpflege setzt auf das Mikrobiom
boerse-global.de, 26.01.26 01:44 Uhr
Mayr-Medizin, Darmkur
Die traditionelle F.X. Mayr-Kur setzt heute auf personalisierte ...
Mayr-Medizin 2026: Darmkur wird zur personalisierten Immuntherapie
boerse-global.de, 18.01.26 06:24 Uhr
Postbiotika, Gesundheitsmarkt
Postbiotika erobern den Gesundheitsmarkt
boerse-global.de, 17.01.26 12:09 Uhr
Darm-Reset, Personalisierte
Der Darm-Reset entwickelt sich 2026 zum ganzheitlichen Gesundheitskonzept ...
Darm-Reset 2026: Personalisierte Mikrobiom-Strategien lösen Pauschal-Kuren ab
boerse-global.de, 16.01.26 22:55 Uhr
Darmgesundheit, Schlüssel
Die Forschung erkennt das Darm-Mikrobiom als zentralen Faktor ...
Darmgesundheit rückt als Schlüssel für Wohlbefinden in den Fokus
boerse-global.de, 12.01.26 06:54 Uhr
Postbiotika, Probiotika
Postbiotika gelten als präzisere Alternative zu Probiotika ...
Postbiotika lösen Probiotika als Hoffnungsträger fürs Gehirn ab
boerse-global.de, 05.01.26 04:53 Uhr
Postbiotika, Geister-Mikroben
Inaktive Mikroben wie Postbiotika und Parabiotika revolutionieren ...
Postbiotika: Die Geister-Mikroben erobern 2026 die Regale
boerse-global.de, 31.12.25 03:52 Uhr
Postbiotika, Revolution